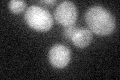
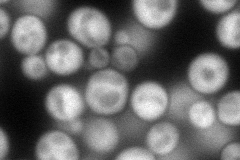
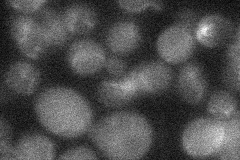
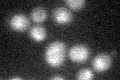

View description
Galactose-1-phosphate uridyl transferase, synthesizes glucose-1-phosphate and UDP-galactose from UDP-D-glucose and alpha-D-galactose-1-phosphate in the second step of galactose catabolism
Localization:
Intensity:
Fold change:
Significance:
-
C’ GFP library in SD
below threshold17.19 -
N' NOP1pr-GFP in SD
cytosol130.628 -
N' TEF2pr-mCherry in SD

cytosol225.2 -
N' NATIVEpr-GFP in SD
below threshold18.2996 -
N' TEF2pr-VC and Cyto-VN in SD

cytosol65.6649 -
C’ GFP library in SD+DTT

cytosol17.281No -
C’ GFP library in SD+H2O2

cytosol17.971.04No -
C’ GFP library in Starvation Media
cytosol28.781.67No -
C’ GFP library on the background of Pup2-DaMP

below threshold -
C’ GFP library on the background of CCT mutant

below threshold18.23241.06011No
